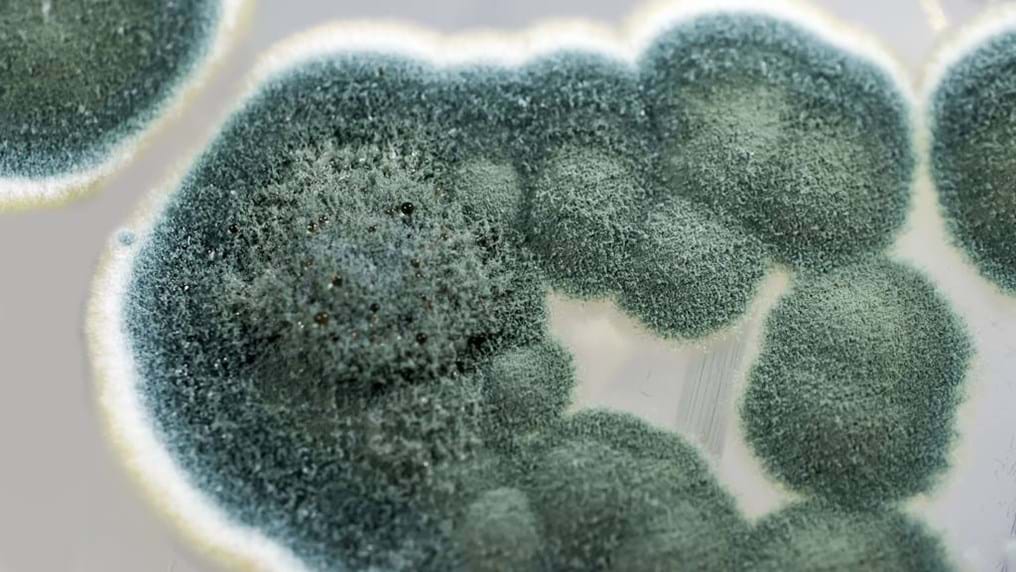

Day 9: D-Day: a day chemical engineers should remember
5th June 2014
Author: Geoff Maitland, IChemE President 2014–2015.
Most of my blog entries are about celebrating the achievements of chemical engineers now. But 6 June 2014 marks the 70th anniversary of the D-Day landings, when British, US and Canadian forces invaded the coast of Northern France in Normandy. It was the biggest amphibious assault in military history.
It was also a point in history when chemical engineers made a major contribution, which could easily be forgotten, that we should remember with pride.
The landings were the first stage of Operation Overlord - the invasion of Nazi-occupied Europe - and were intended to bring World War Two to an end.
Over 425,000 Allied and German troops were killed, wounded or went missing during the Battle of Normandy. This figure includes over 209,000 Allied casualties, with nearly 37,000 dead amongst the ground forces and a further 16,714 deaths amongst the Allied air forces.
The number of people who died could have been a lot higher if it wasn't for the efforts of the penicillin pioneers.
Many people will be aware of the contribution of Alexander Fleming and Howard Florey who discovered and identified the potential of penicillin to kill bacteria.
There are also many more less well-known stories of pioneers such as Jasper Kane and John McKeen who were working for Pfizer in the first half of the 20th century.
Without their work antibiotics would not have reached the soldiers in the closing stages of World War II to treat the 150,000 soldiers wounded in the D-Day landings alone.
Kane and McKeen’s contribution was the industrial-scale production of penicillin via deep-tank fermentation and gave hope and a lifeline to survive the carnage of D-Day.
It's an amazing story and can be read in full with an excellent article written in 2010 by the former editor of tce magazine, Claudia Flavell-While, called Pfizer's penicillin pioneers.
ChemEng365 blog
Geoff Maitland launched this blog during his IChemE presidency in 2014. ChemEng365 features 365 chemical engineering successes and achievements throughout his year-long presidency.